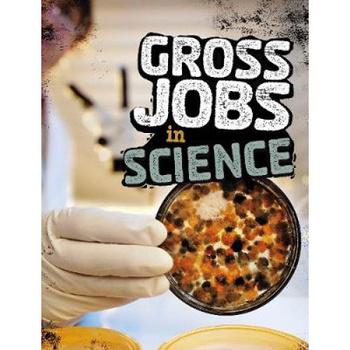

SCHOOL



READING LIST YEAR 8 DivergentbyVeronicaRoth DiaryofaYoungGirlbyAnneFrank DraculabyBramStoker FrankensteinbyMaryShelley ENGLISH



SCHOOL READING LIST YEAR 9 1984byGeorgeOrwell TheFamilyRomanov:Murder,Rebellion,andtheFallofImperialRussia, byCandaceFleming RomeoandJuliet(adaptation) EndgamebyMalorieBlackman MatchedbyAllieCondie LoveHurtsbyvariousauthorsbuteditedbyMalorieBlackman TheCuriousIncidentoftheDogintheNightTime ENGLISH



SCHOOL READING LIST YEAR 9 ThePowerbyNaomiAlderman ChasingtheStarsbyMalorieBlackman TheMazeRunner(&sequels)byJ.Dashner Divergent(&sequels)byVeronicaRoth TheBeekeeperofAleppobyChristyLefteri ENGLISH



SCHOOL READING LIST YEAR 10 NeverLetMeGobyKazuoIshiguro WomaninBlackbySusanHill TheKiteRunnerbyKhalidHosseini AnitaandMebyMeeraSyal TheColorPurplebyAliceWalker IKnowWhyaCagedBirdSingsbyM.Angelou ENGLISH



SCHOOL READING LIST YEAR 10 BlackFlamingobyDeanAtta ThePerksofBeingaWallflowerbyS.Chbosky TheLovelyBonesorLuckybyAliceSebold TheBookThiefbyMarcusZusak ENGLISH



SCHOOL READING LIST YEAR 11 NeverLetMeGobyKazuoIshiguro WomaninBlackbySusanHill TheKiteRunnerbyKhalidHosseini AnitaandMebyMeeraSyal TheColorPurplebyAliceWalker IKnowWhyaCagedBirdSingsbyM.Angelou ENGLISH



SCHOOL READING LIST YEAR 11 BlackFlamingobyDeanAtta ThePerksofBeingaWallflowerbyS.Chbosky TheLovelyBonesorLuckybyAliceSebold TheBookThiefbyMarcusZusak ENGLISH



SCHOOL READING LIST YEAR 7 MichaelJordan:Volume72-LittlePeople,BIGDREAMS MuhammadAli:Volume22-LittlePeople,BIGDREAMS MeganRapinoe:Volume55-LittlePeople,BIGDREAMS WilmaRudolph:Volume27-LittlePeople,BIGDREAMS EvonneGoolagong:Volume36 LittlePeople,BIGDREAMS JesseOwens:Volume42-LittlePeopleBIGDREAMS PE



SCHOOL READING LIST YEAR 7 UltimateFootballHeroesCollection10BooksSet: Rashford,Ronaldo,Messi,Kane,Son,Grealish,Fernandes,Haaland, Neymar,Sancho SomersaultsandDreamsSeriesCateShearwaterCollection3BooksSet PE



SCHOOL READING LIST YEAR 8 LeapbyGevaMentor IKnowThistoBeTrue:SimoneBiles:OnFamily,Confidence, andPersistence HowtoBuildaCar:TheAutobiographyoftheWorld'sGreatest Formula1Designer YouCanDoIt:HowtoFindYourTeamandMakeaDifference NileWilsonbyMyStory PE



SCHOOL READING LIST YEAR 9 ALifeWithoutLimits:AWorldChampion'sJourney Fierce:HowCompetingforMyselfChangedEverything DrivingForwards:Ajourneyofresilienceandempowermentafter life-changinginjury YouAreaChampionbyMarcusRashford TheMechanic:TheSecretWorldoftheF1Pitlane PE



SCHOOL READING LIST YEAR 10 FastGirls:ANovelofthe1936Women'sOlympicTeambyEliseHooper WhyWeKneelHowWeRisebyMichaelHolding BetweentheLines:TheAutobiographybyVictoriaPendleton TourdeForce:Myhistory-makingTourdeFrance ComingUpforAir:WhatILearnedfromSport,FameandFatherhoodby TomDaley PE



SCHOOL READING LIST YEAR 7 - 9 NoBalletShoesinSyriabyCatherineBruton TheNutcrackerbyE.T.AHoffmann BalletShoesbyNoelStreatfield ATimetoDancebyT.VPadma-Veda FlyHighCrewbyAshleyandJordanBanjo SwanBoybyNikkiSheehan DANCE



SCHOOL READING LIST YEAR 7 - 9 Summer'sDreambyCathyCassidy CoyoteSummerbyMimiThebo TheBookofDancebyDorlingKindersley BhangraandBollywoodbyAnnaClaybourne DANCE CONTI



SCHOOL READING LIST YEAR 7 - 9 BrazilianDancebyLizGogerly StreetDancebyDJHooch HipHopbyLoriMortensen Something'sComing,SomethingGoodWestSideStoryandtheAmericanImaginationbyMishaBerson WestSideStory-CulturalPerspectivesonanAmericanMusicalbyMisha Berson DANCE



SCHOOL READING LIST YEAR 10 - 11 TheSmellofOtherPeople'sHousesbyBonnie-SueHitchcock DanceofShadowsbyYelenaBlack StarDancerbyBethWebb SwingTimebyZadieSmith ButThenICameBackbyEstelleLaure ArtWithoutBoundaries,TheWorldofModernDance,JackAnderson DANCE



SCHOOL READING LIST YEAR 10 - 11 EvolvedbyDarcyBussell ALifeofDanceandDreamsbyAlvinYudkoff IntroductiontoModernDanceTechniquesbyJoshuaLeg OutofLinebyJudithMackrell DANCE



SCHOOL READING LIST YEAR 10 - 11 LittleLeaders:ExceptionalMeninBlackHistorybyVashtiHarrison HopeinaBalletShoebyMichaelaDePrince Mao'sLastDancerbyLiCunxin TheMagicalWorldofBalletbyLisaMile DANCE



SCHOOL READING LIST YEAR 7 WriteYourOwnScriptsbyMatthewOldham GhostBoysbyJewellParkerRhodes ComedyActingforTheatre:theartandcraftofperformingincomedies byProfessorSidneyHoman CollectedGrimmTalesbyCarolAnnDuffy Sparkleshark:aplaybyPhilipRidley DRAMA



SCHOOL READING LIST YEAR 8 OurDayOutbyWillyRussell Noughts&CrossesbyMalorieBlackman RomeoandJulietbyWilliamShakespeare KindertransportbyDianeSamuels TheBoyintheStripedPyjamasbyJohnBoyneandAngusJackson KS3Playtextsuggestions-KeyStageThreeDrama DRAMA



SCHOOL READING LIST YEAR 9 TeachersbyJohnGodber TheCompleteStanislavskyToolkitbyBellaMerlin TooFastbyDouglasMaxwell OurTeacher'saTrollbyDennisKelly TheStorytellerSequencebyPhilipRidley DRAMA



SCHOOL READING LIST YEAR 10 TheCompleteBrechttoolkitbyStephenUnwin AnIntroductiontoTechnicalTheatrebyTalSanders CharacterCostumeFigureDrawing:step-by-stepdrawingmethodsfor theatrecostumedesignersbyProfessor TanHuaixiang TheFranticAssemblybookofdevisingtheatrebyScottGraham ABeginner'sGuidetoDevisingTheatrebyTashiGore DRAMA



SCHOOL READING LIST YEAR 11 MyMotherSaidINeverShouldbyCharlotteKeatley DNAbyDennisKelly Plays1byJohnGodber ThePlayofAnimalFarmbyPeterHall BloodBrothersbyWillyRussell DRAMA



SCHOOL READING LIST YEAR 7 - 9 HorribleGeographies: Earth-ShatteringEarthquakes,CrackingCoasts,FreakyPeaks,Monster Lakes,Bloomin'Rainforests,StormyWeather,ViolentVolcanoes, DesperateDeserts,OdiousOceans,RagingRivers NoOneIsTooSmalltoMakeaDifferencebyGretaThunberg AShortHistoryofEverythingbyBillBryson FactfullnessbyHansRosling GEOGRAPHY



SCHOOL READING LIST YEAR 10 - 11 PrisonerofGeographybyTimMarshall ThePowerofGeographybyTimMarshall Population10BillionbyDannyDorling ThereisNoPlanetBbyMikeBerners-Lee AVeryShortIntroductiontoDevelopment/Food JohnKrebs DeadAidbyDambisaMoyo GEOGRAPHY



SCHOOL READING LIST YEAR 10 - 11 RivalsbyBillEmmet WhenRiversRunDrybyFredPearce DisasterbyChoicebyIlanKelman TheBottomBillioinbyPaulCollier GEOGRAPHY



SCHOOL READING LIST YEAR 7 HorribleHistoriesSeries HorribleGeographySeries TinBoyandWorldBurnDownbySteveCole ClimateCrisisforBeginners 100ThingstoKnowaboutHistory HISTORY
HISTORY



SCHOOL READING LIST YEAR 8 100ThingstoKnowAboutPlanetEarth ClimateCrisisforBeginners TheBoyintheStripedPyjamas TrashbyAndyMulligan ScavengersbyDarrenSimpson






SCHOOL READING LIST YEAR 9 ClimateEmergencyAtlas DeadlyHistorySeries:BubonicPlague,HorrorofWWIHorrorofthe Holocaustetc Greta’sStory:StoryofGretaThunberg HISTORY



SCHOOL READING LIST YEAR 10 TenMaps:thepowerofgeographybyTimMarshall PrisonersofGeography:Ourworldexplainedin12simplemaps Putin’sRussia:TheriseofadictatorbyDarylCunningham HISTORY



SCHOOL READING LIST YEAR 7 What’sThePointofScience?byDKDarylCunningham 110ThingstoKnowAboutScience Robot:meetthemachinesofthefuture ThePeriodicTablebyTomJackson WhyisSnotGreen? SCIENCE



SCHOOL READING LIST YEAR 8 TheSciencebook.Bigideassimplyexplained MindMaps:Physics:HowtoNavigatetheWorldofSciencebyDrBenStill MindMaps:Biology:HowtoNavigatetheLivingWorldByDrHelenPilcher CorpseTalk:GroundBreakingScientists GrossJobsinSciencebyAdamMurphy SCIENCE



GraphicSciencebyDarrylCunningham ScienceTalesbyDarrylCunningham ForensicScienceDK SCHOOL READING LIST YEAR 9 SCIENCE



SCHOOL READING LIST YEAR 10 BriefAnswerstotheBigQuestionsStephenHawkins Howto.AbsurdScientificAdviceforCommonReal-WorldProblemsby RandallMunro Whatif?SeriousScientificAnswerstoAbsurdHypotheticalQuestionsby RandallMunroe SCIENCE



SCHOOL READING LIST YEAR 7 What’sthePointofMaths?DK 100MathsWordsExplained AnAnswerforEverything:200infographicstoexplainourcrazyworld MurderousMathsbyKjartanPoskitt MATHS



SCHOOL READING LIST YEAR 8 What’sthePointofMaths?DKand100Mathswordsexplained TheMathsbookbyDKBigideassimplyexplained MurderousMathsbyKjartanPoskitt 1089andAllThat:AJourneyintoMathematicsbyDavidAcheson TheNumberDevilbyHMEnzensberger ThinkofaNumberbyJohnnyBall MATHS



SCHOOL READING LIST YEAR 8 ABeautifulMindbySylviaNasar TheBoyWhoLovedMath:TheImprobableLifeofPaulErdös Blockhead:TheLifeofFibonacci InfinityandMe OnaBeamofLight:AStoryofAlbertEinstein SnowflakeSeashellStarbyAlexBellosandEdmundHarriss MATHS



SCHOOL READING LIST YEAR 8 CanyouSolvemyProblems?byAlexBellos TheNumberDevilbyHansMagnusEnzensberger TheIndisputableExistenceofSantaClausbyHannahFryandThomas OléronEvans Aha!Insight&aha!GotchabyMartinGardner TheThrillingAdventuresofLovelaceandBabbagebySydneyPadua The'UncleAlbert'SeriesbyRussellStannard MATHS



SCHOOL READING LIST YEAR 9 What’sthePointofMaths?DK 100MathsWordsExplained MurderousMathsbyKjartanPoskitt MATHS



SCHOOL READING LIST YEAR 10 Humblepi:acomedyofmathserrorsbyMattParker Alex’sAdventuresinNumberlandbyAlexBellos Howlongisapieceofstring?byRobEastawayandJeremyWyndham WhydoBusescomeinThrees?byRobEastawayandJeremyWyndham Alex’sAdventuresinNumberLandbyAlexBellos AlexThroughTheLookingGlassbyAlexBellos MATHS



TheIndisputableExistenceofSantaClaus:TheMathematicsof ChristmasbyDrThomasOléronEvansandHannahFry UnclePetrosandGoldbach’sConjecturebyApostolosDoxiadis TheCuriousIncidentoftheDogintheNight-TimebyMarkHaddon TheMontyHallProblem:BeyondClosedDoorsbyRobDeaves Mathematics:TheNewGoldenAgebyKeithDevlin TheCodeBookbySimonSingh SCHOOL READING LIST YEAR 10 MATHS



SCHOOL READING LIST YEAR 10 Zero:TheNothingthatisbyRobertKaplan TheMusicofthePrimesbyMarcusduSautoy TheGCHQPuzzleBooks WhydoBusesComeinThrees?byRobEastawayandJeremyWyndham AlexThroughtheLookingGlass:Howlifereflectsnumbersandnumbers reflectlifebyAlexBellos MATHS



SCHOOL READING LIST YEAR 7 13PaintersChildrenShouldKnowbyFlorianHeine 13PaintingsChildrenShouldKnowbyAngelaWenzel 13ArtTechniquesChildrenShouldKnowbybyAngelaWenzel ART



WeareArtists:womenwhomadetheirmarkontheworldbyKariHerbet 50NamesYouNeedtoKnowinArtandDesignbyJaneBingham FridaKahloTheartistintheblueHouse SCHOOL READING LIST YEAR 8 ART


SCHOOL READING LIST YEAR 9 TheArtofProtestbyDeNichols HowTechnologyworks ART


IKnowanArtist:Theinspiringconnectionsbetweentheworld'sgreatest artistsbySusieHodge ArtMattersbyNeilGaiman SCHOOL READING LIST YEAR 10 ART



SCHOOL READING LIST YEAR 7 HowTechnologyWorksDK Robot:meetthemachinesofthefuture ExperimentalDrones ComputerCoding:PythonprojectsforkidsbyCarolVorderman TECHNOLOGY



SCHOOL READING LIST YEAR 8 Inventions&AwesomeFactsfromMuslimCcivilizationbyNational GeographicKids 100ThingstoKnowaboutComputersandCoding TheTechBehind:ElectricCars TheTechBehindSelf-DrivingCars TECHNOLOGY


SCHOOL READING LIST YEAR 9 HowTechnologyWorksDK TheBookofInventions:amazingideasthatchangedtheworldbyTim Cooke TECHNOLOGY